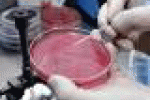
Caso di Tbc in scuola del Modenese - ANSA.it

Notizie Sanità Medicina Salute da Google News

News ItalianeFecondazione assistita: bambini nascono sani anche da embrioni 'malati' prima volta esito positivoNews ItalianePer quel che riguarda la fecondazione assistita, i bambini possono nascere sani anche da embrioni 'malati', ovverosia anche... ...

Leonardo.itSabato TURBOLENTO sull'Italia: maltempo soprattutto tra Lombardia, nord-est e regioni tirrenicheLeonardo.itAria sempre più fredda si approssima alle Alpi e le valicherà in giornata portando maltempo su Lombardia, Emilia-Romagna e... ...

Data manager onlineDurex presenterà la nuova "condom emoji"Stadio24.comPrima di tutto vi è il rischio di una gravidanza indesiderata data la possibile presenza di spermatozoi nel precum ( il liquido prodotto dai testicoli ed espulso dal pene nel... ...

ANSA.itCaso di Tbc in scuola del ModeneseANSA.it(ANSA) - MODENA, 20 NOV - C'è un caso di Tbc polmonare in un giovane che frequenta un istituto superiore a Castelfranco Emilia, nel Modenese. Lo rende noto l'Ausl di Modena. Il paziente, attualmente... ...

IntelligonewsItaliani medici improvvisati, ma sul web è allarme sui pazienti 2.0IntelligonewsIl fenomeno di consultare internet al manifestarsi di un sintomo o di una semplice alterazione fisica è dilagante, spesso assume dimensioni piuttosto... ...

Quotidiano.netTaglia le orecchie al cane con le forbici da cucina: denunciatoQuotidiano.netPistoia. L'uomo non ha proceduto ad alcuna profilassi e il cane era affetto da infezione. L'animale è stato sequestrato e trasferito in una clinica... ...